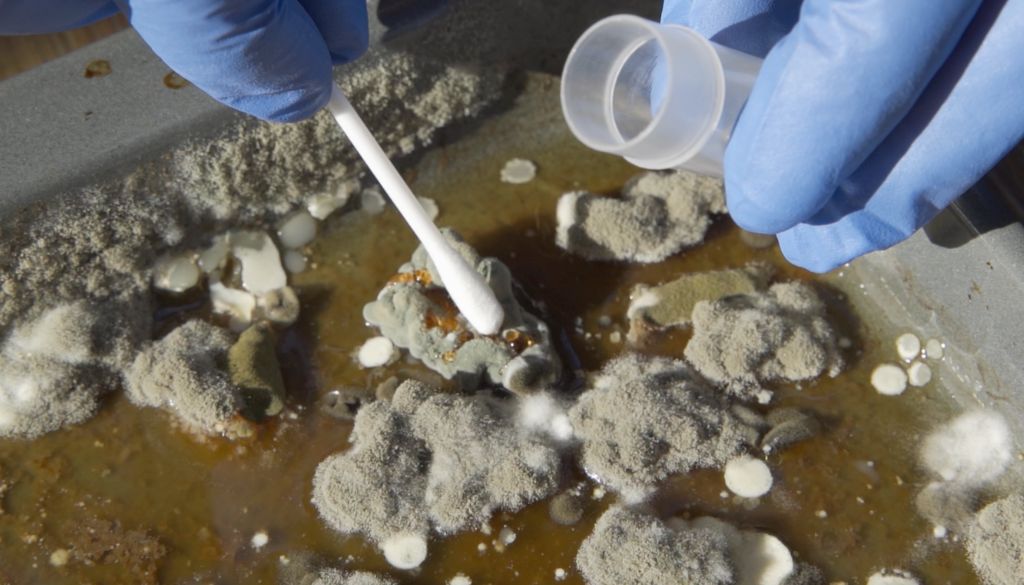
simulacion

Informe revela 131 millones de personas en latinoamérica no tiene acceso a dieta saludable
El informe de Naciones Unidas Panorama de la seguridad alimentaria y nutricional 2022, revela que el 22,5% de las personas en América Latina y el Caribe no tienen los medios suficientes para acceder a una dieta saludable. Elste informe indica que 131,3 millones de personas en la región no pudieron costear una dieta saludable en […]
Desigualdad en las vacunas a nivel mundial, según revela primer informe de OMS desde covid-19

Este es el primer informe que recoge las repercusiones de la COVID-19 en los mercados de vacunas OMS ofreció el primer informe sobre el mercado mundial de vacunas en 2022, el cual muestra las desigualdades en cuanto a la distribución. En ese sentido, detalló que este desequilibrió no se produce únicamente en las vacunas contra […]
Los 19 hongos más peligrosos para la salud, según OMS
La primera lista de los hongos que constituyen una amenaza para la salud OMS publicó un informe que incluye su primera lista (en inglés) de «patógenos fúngicos prioritarios»: un catálogo de los 19 hongos más peligrosos para la salud pública. Esta lista OMS de patógenos fúngicos prioritarios (FPPL) es la primera iniciativa de ámbito mundial […]
América Latina y el Caribe: la región que envejece más rápido en el mundo, según informe

Según el informe para 2085, América Latina y el Caribe será la primera región en la que una de cada tres personas tendrá más de 65 años. El informe titulado «Envejecer en América Latina y el Caribe: protección social y calidad de vida de las personas mayores» fue presentado por el Banco Interamericano de Desarrollo, […]
Mejora la lucha contra el tabaquismo en America Latina

La Organización Panamericana de la Salud informó ayer que unos 900 millones de personas de 35 países de América, el 96% de la población, cuentan con al menos una de las seis medidas de control del tabaco recomendadas por la Organización Mundial de la Salud, un 50% más que las registradas el año 2007. Según […]
¿Cómo es la salud de los que migran a otros países?

En todo el mundo, millones de refugiados y migrantes, como los trabajadores migrantes poco cualificados, viven en situación de vulnerabilidad y de salud que la población de sus países de acogida, sobre todo cuando sus condiciones de vida y de trabajo son deficientes. Esta es una de las conclusiones del primer Informe mundial de la […]
Mujeres en el sector salud ganan 24 % menos que los hombres

Un análisis de la OMS y la OIT revela que las mujeres se enfrentan a una brecha salarial de género mayor que en otros sectores económicos. Las mujeres en el sector de la salud y el cuidado enfrentan una brecha salarial de género más grande que en otros sectores económicos, ganando en promedio un 24 […]
OMS publica lista de bacterias para las que se necesitan con urgencia nuevos antibióticos

La Organización Mundial de la Salud publicó hoy el primer informe sobre la cartera de vacunas actualmente en desarrollo, con el fin de prevenir infecciones causadas por patógenos bacterianos resistentes a los antimicrobianos (RAM). El análisis de la OMS, señala la necesidad de acelerar los ensayos de vacunas relacionadas con la resistencia a los antimicrobianos […]
